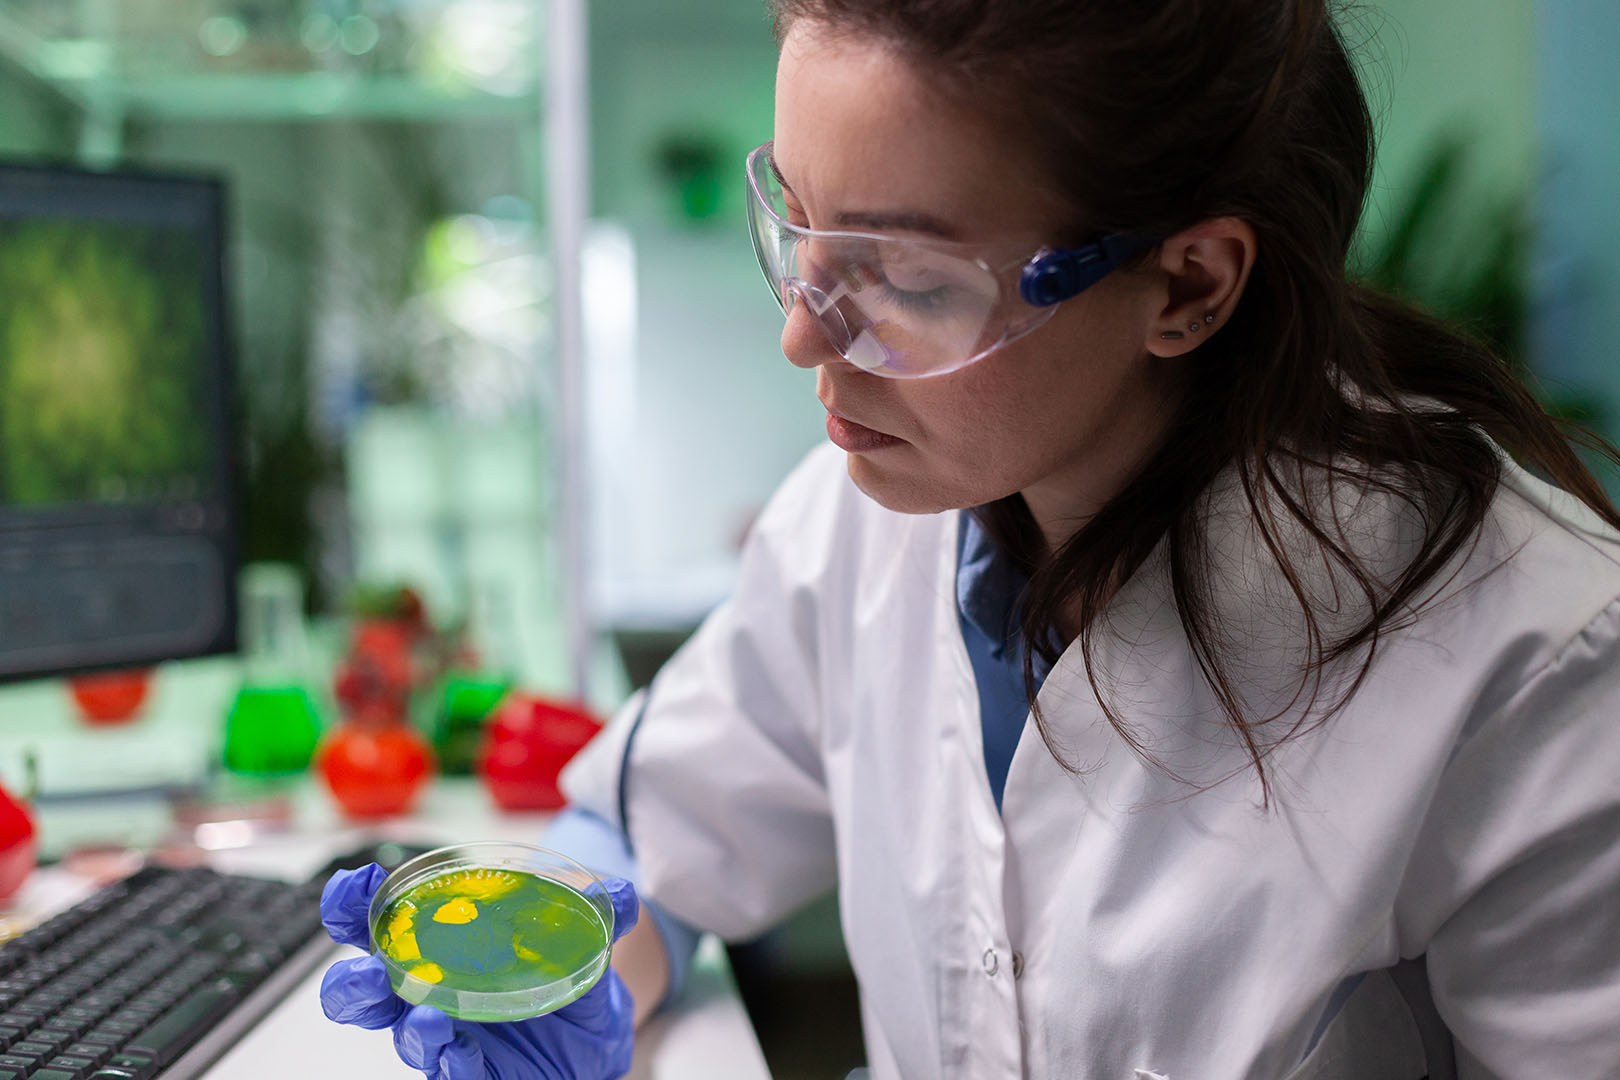

INGENIERÍA EN NANOTECNOLOGÍA
“Explora el mundo a nanoescala y transforma el futuro con innovación.”
La nanotecnología es una ciencia aplicada que permite manipular y desarrollar materiales a escala nanométrica para potenciar avances en diversas áreas como la nanomedicina, energías renovables, tratamiento de aguas, remediación ambiental y el diseño de materiales sostenibles. Prepárate para impactar el mundo con soluciones tecnológicas innovadoras.



¿ES LA INGENIERÍA EN NANOTECNOLOGÍA PARA TI?

DESCUBRE SI ESTA CARRERA ESTÁ HECHA PARA TI.
1. ¿Te interesan la física, la química y las ciencias de materiales?
2. ¿Disfrutas de la investigación y el desarrollo tecnológico?
3. ¿Te motiva crear soluciones sostenibles para problemas globales?
Si respondiste “sí”, esta carrera es perfecta para ti.
4. ¿Te apasiona trabajar en proyectos innovadores y multidisciplinarios?
5. ¿Tienes curiosidad por explorar los límites de la ciencia a nanoescala?
Perfil de ingreso
El aspirante ideal a esta carrera debe contar con:
Habilidades y capacidades transversales:
Capacidad para analizar y transmitir información de diversas fuentes.
Habilidad para comunicar ideas de forma clara, oral y escrita.
Resolución de problemas mediante métodos establecidos.
Aprendizaje autónomo y disposición para trabajar en equipo.
Compromiso con la ética, la inclusión y el respeto por la diversidad.
Habilidades específicas:

Perfil de Egreso
Como Ingeniero en Nanotecnología, serás capaz de:
- Diseñar y desarrollar procesos de producción de nanomateriales a nivel laboratorio e industrial.
- Aplicar técnicas de síntesis y caracterización para asegurar la calidad de los nanomateriales.
- Innovar en soluciones tecnológicas basadas en nanotecnología para diversas industrias.
- Analizar la viabilidad técnica y económica de proyectos de nanotecnología.
- Actuar con una visión ética, inclusiva y sostenible en todos los ámbitos de la profesión.
¿Dónde podrás trabajar?
Tu campo laboral abarca:







Ocupaciones profesionales
Podrás desempeñarte como:
- Desarrollador de productos nanoestructurados.
- Especialista en caracterización de nanomateriales.
- Ingeniero de procesos nanotecnológicos.
- Consultor en nanotecnología y normatividad.
- Gerente de proyectos de innovación tecnológica.
- Investigador y docente en nanotecnología.
- Emprendedor en el desarrollo de tecnologías basadas en nanomateriales.

Cambia el mundo a escala nano
Con la Ingeniería en Nanotecnología, liderarás la innovación en sectores clave, desarrollando materiales y soluciones que impactan positivamente en la sociedad y el medio ambiente. ¡Forma parte del futuro con la UTEZ, Territorio de calidad!

